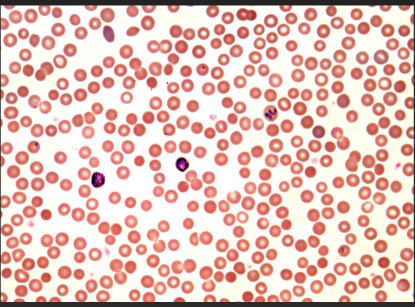
<p></p>

bio lab practical PROTISTS
1/10
There's no tags or description
Looks like no tags are added yet.
Name | Mastery | Learn | Test | Matching | Spaced | Call with Kai |
|---|
No analytics yet
Send a link to your students to track their progress
11 Terms

protist, Photosynthetic algae, green algae, Chlamydomonas, 2 flagella

protist, photosynthetic algae, green algae, spirogyra, non-motile

protist, photosynthetic algae, green algae, volvox, 2 flagella

protist, photosynthetic algae, diatoms, non-motile, silica cell walls

protist, photosynthetic algae, dinoglagellates, cellulose cell walls, some produce “red tide” toxins, peridinium, 2 flagella

protist, photosynthetic algae, euglenoids, euglena

protists, heterotrophic protozoa, amoebas, amoeba, psudopod

protists, heterotrophic protozoa, flagellates, trypansoma, parasitic, 1 flagella

protists, heterotrophic protozoa, ciliates, paramecium, capable of conjugation and binary fission, cillia
protists, heterotrophic protozoa, plasmodium, cause of malaria, non-motile

protist, heterotrophic protozoa, glabigerina, calcium carbonate shell TEST, pseudopod